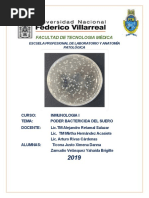

0% encontró este documento útil (0 votos)
65 vistas27 páginasProceso de Atención en Enfermería Comunitaria
El documento describe el proceso de atención de enfermería comunitario. Explica que el proceso de atención de enfermería consiste en una serie de etapas ordenadas lógicamente para planificar cuidados personalizados y cubrir las necesidades de los usuarios, familias y comunidades. Además, describe las teorías de Dorothea Orem sobre el autocuidado, déficit de autocuidado y sistemas de enfermería, las cuales son fundamentales para el proceso de atención de enfermería comunitario. Finalmente, detalla las et
Cargado por
Allison A. MejicanoDerechos de autor
© © All Rights Reserved
Nos tomamos en serio los derechos de los contenidos. Si sospechas que se trata de tu contenido, reclámalo aquí.
Formatos disponibles
Descarga como PDF, TXT o lee en línea desde Scribd
0% encontró este documento útil (0 votos)
65 vistas27 páginasProceso de Atención en Enfermería Comunitaria
El documento describe el proceso de atención de enfermería comunitario. Explica que el proceso de atención de enfermería consiste en una serie de etapas ordenadas lógicamente para planificar cuidados personalizados y cubrir las necesidades de los usuarios, familias y comunidades. Además, describe las teorías de Dorothea Orem sobre el autocuidado, déficit de autocuidado y sistemas de enfermería, las cuales son fundamentales para el proceso de atención de enfermería comunitario. Finalmente, detalla las et
Cargado por
Allison A. MejicanoDerechos de autor
© © All Rights Reserved
Nos tomamos en serio los derechos de los contenidos. Si sospechas que se trata de tu contenido, reclámalo aquí.
Formatos disponibles
Descarga como PDF, TXT o lee en línea desde Scribd